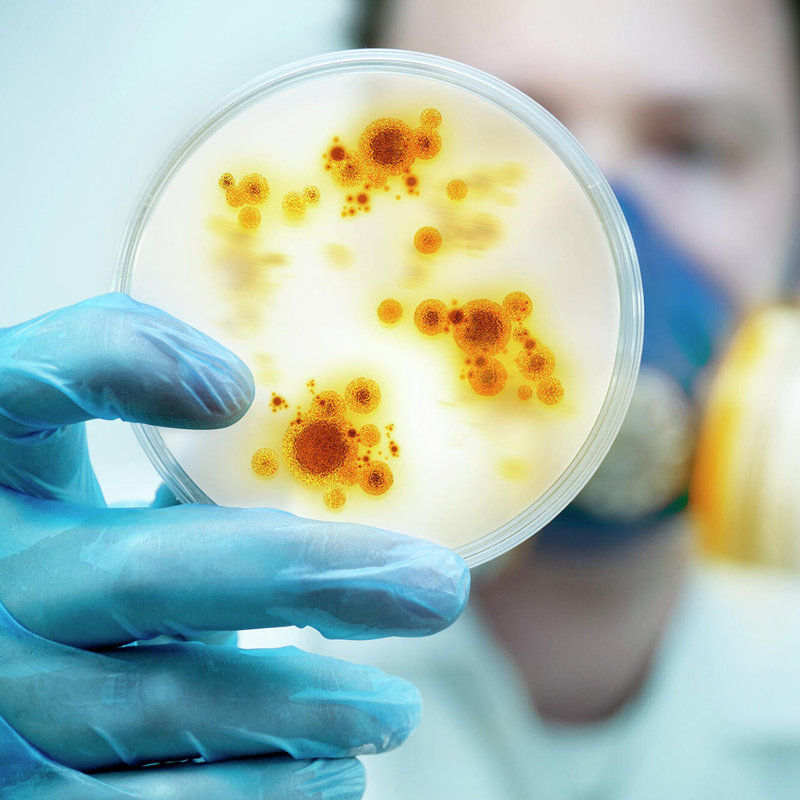
water system in pharma industry

Biocell provides professional solutions for purified water system, water for injection system, pure steam system, storage and distribution system in the biotechnology industry: vaccine, blood products, cells, antibody drugs, recombinant protein and other fields.
Pharmaceutical water is an important raw material in the production process of various biological products and biochemical drugs. It participates in the whole production process, including raw material production, separation and purification, finished product preparation, washing process, cleaning process and disinfection process.
Therefore, in the production process of biological products and biochemical drugs, pharmaceutical water system is a crucial component.

Blood products refer to plasma protein components separated, purified or prepared by recombinant DNA technology from healthy human plasma or specially immunized human plasma, as well as blood cell visible components.

Purified water and water for injection are the most widely used raw materials and excipients in the vaccine and other biological products and even pharmaceutical preparations industry, and their quality will directly affect the quality of the final products.
Biochemical drugs generally refer to the basic substances of life extracted from animals, plants and microorganisms, which can also be semi synthesized biochemically or made by modern biotechnology, such as amino acids, peptides, proteins, enzymes, coenzymes, polysaccharides, nucleotides, lipids and biogenic amines, as well as their derivatives, degradants and structural modifiers of macromolecules.

Diagnostic reagents refer to the diagnostic reagents prepared by the principles or methods of immunology, microbiology, molecular biology, etc. and used in vitro for the diagnosis, detection and epidemiological investigation of human diseases.

Antibiotics refer to a class of secondary metabolites produced by microorganisms (including bacteria, fungi, actinomycetes) or higher animals and plants in the course of life, which have anti pathogen or other activities and can interfere with the development of other living cells. Antibiotics commonly used in clinic include extracts from microbial cultures and chemical or semi synthetic compounds.

Health (functional) food is a kind of food, which has the common characteristics of general food, can adjust the human body's function, and is suitable for specific people to eat, but not for the purpose of curing diseases.
In the field of biotechnology, water with various quality standards will be used in the manufacturing process of products, which is collectively referred to as pharmaceutical water.
Pharmaceutical water produced by pharmaceutical water systems is an important raw material in the production process of various biological products and biochemical drugs. It participates in the whole production process, including raw material production, separation and purification, finished product preparation, washing process, cleaning process and disinfection process.
Therefore, in the production process of biological products and biochemical drugs, pharmaceutical water system is a crucial component.


